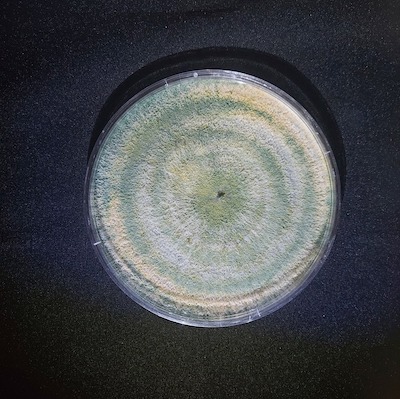

Vittia lança TRICHO-TURBO OD: inovação biológica no combate a fungos de solo
O produto desenvolvido pela área de P&DI da Companhia é composto por cepa exclusiva, que apresenta resultados superiores no controle patógenos de solo em diferentes culturas
A Vittia, empresa brasileira referência em tecnologia biológica para defesa e nutrição especial de plantas, apresenta ao mercado o Tricho-Turbo OD, um fungicida microbiológico que representa um avanço significativo no controle de doenças de solo.
Desenvolvido a partir do trabalho de bioprospecção da área de P&DI da Companhia, o lançamento é composto por uma cepa exclusiva, o Trichoderma asperellum BVF24, e reforça a vocação da empresa no robusto investimento para o desenvolvimento de pesquisas para oferecer soluções diferenciadas ao mercado agrícola.
O Tricho-Turbo OD é eficaz no controle da podridão cinzenta do caule, causada pelo fungo Macrophomina phaseolina, em diversas culturas. Sua formulação líquida em dispersão em óleo (OD) oferece proteção aos esporos do fungo garantindo maior virulência a campo. Além de proteger a lavoura, o produto estimula o crescimento das plantas, gerando mais vigor e produtividade.
Com ação preventiva, o Tricho-Turbo OD pode ser aplicado diretamente sobre a palhada, permitindo o controle de doenças antes mesmo de se instalarem no solo. Além disso, o produto pode ser utilizado no tratamento de sementes, no sulco de plantio e por pulverização. Essas práticas aumentam a flexibilidade de uso do produto e otimizam as aplicações de forma eficiente.
O lançamento do Tricho-Turbo OD reforça o compromisso da Vittia com a inovação e a sustentabilidade, oferecendo aos produtores uma ferramenta eficaz e segura para o manejo fitossanitário de culturas de grande importância na agricultura brasileira. Com este novo produto, a empresa consolida sua posição como líder em soluções biológicas, contribuindo para uma agricultura mais sustentável e produtiva.
Sobre a Vittia
A Vittia (BVMF:VITT3) nasceu com um propósito: cuidar das mais diferentes culturas do agronegócio brasileiro, levando produtividade, rentabilidade e aprimoramento do balanço socioambiental. A partir de uma cultura de cuidado e de inovação, a Vittia oferece soluções biotecnológicas para defesa e nutrição especial de plantas, contribuindo para uma agricultura cada dia mais produtiva e sustentável. Com a maior fábrica de biológicos da América Latina e outras cinco unidades industriais no estado de São Paulo, a Vittia conta mais de 1.100 colaboradores, criando valor por meio da inovação e da ampliação de negócios com aquisições estratégicas no mercado.
O investimento constante em pesquisa, desenvolvimento e tecnologias garante um portfólio completo composto por fertilizantes biológicos, amplo portfólio de controle biológico – inseticidas, acaricidas, fungicidas, bactericidas, nematicidas e adjuvantes, suspensão concentrada, fertilizantes macro e micro, biofertilizantes e sais para a agricultura e pecuária.
O comprometimento com um ecossistema sustentável foi reconhecido pelo Ministério da Agricultura, Pecuária e Meio Ambiente, por meio do Selo Agro+ Integridade, destinado a empresas que desenvolvem boas práticas de gestão de integridade, ética e sustentabilidade. Mais Informações no Site , Youtube, Instagram, Linkedin e Facebook .








